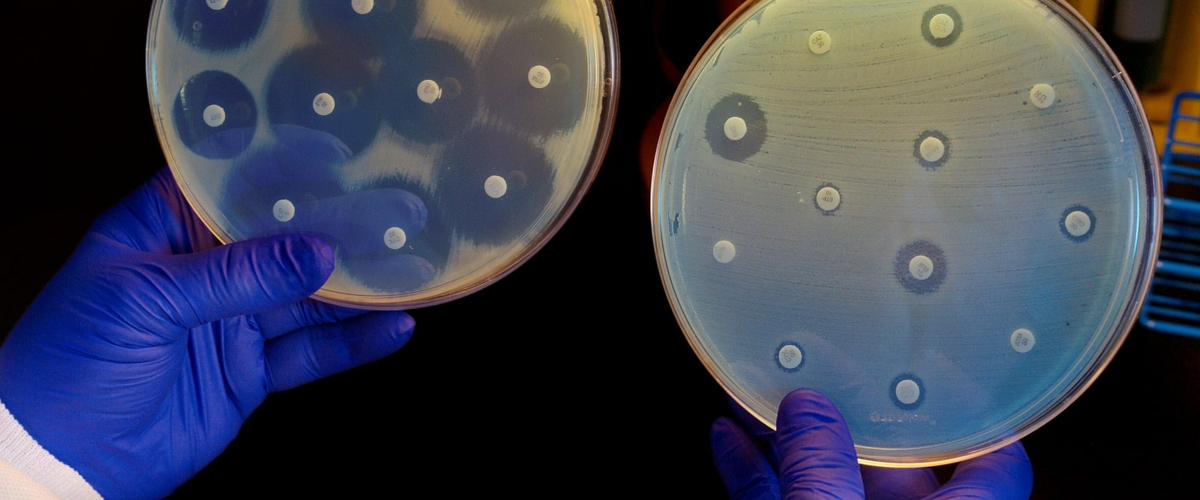
TODO:

Антибиотики дали человечеству возможность лечить целый ряд опасных болезней. Однако бактерии быстро вырабатывают резистентность, так что многие из существующих препаратов уже неэффективны. Между тем, возможности создавать новые антибиотики ограничены.
В поисках новых антибактериальных препаратов исследователи из Массачусетского технологического института обратились к помощи искусственного интеллекта. Команда, о работе которой рассказывает Guardian, скормила алгоритму глубокого обучения информацию об атомной и молекулярной структуре 2500 природных и синтезированных антибиотиков, а также их эффективности против кишечной палочки Escherichia coli.
Затем исследователи попросили программу проанализировать библиотеку из 6000 соединений, тестируемых для лечения различных болезней. Задачей алгоритма было отобрать молекулы, способные эффективно бороться с бактериями, но непохожие по структуре на существующие антибиотики. Это должно было повысить шансы найти соединения, уничтожающие микроорганизмы принципиально новыми способами.
Всего за несколько часов алгоритм выделил несколько веществ-кандидатов. Одно из них, несостоявшееся лекарство от диабета (показало плохие доклинические результаты, а как антибиотик разработчики его даже не рассматривали), выглядело особенно перспективно. Ученые назвали его халицин — в честь искусственного интеллекта HAL из фильма «Космическая одиссея 2001 года». По структуре это соединение не было похоже ни на один известный антибиотик.
Эксперименты подтвердили, что халицин может уничтожать целый ряд лекарственно-устойчивых микроорганизмов, включая возбудителя туберкулеза Mycobacterium tuberculosis и резистентные к новейшим антибиотикам штаммы бактерий из семейства Enterobacteriaceae. Кроме того, препарат вылечил лабораторных мышей от Clostridium difficile и Acinetobacter baumannii с множественной лекарственной устойчивостью.
«Я думаю, что это один из самых мощных антибиотиков, которые были обнаружены на сегодняшний день, — заявил Джеймс Коллинз, биоинженер из команды MIT. — Он обладает очень высокой активностью против широкого спектра устойчивых к антибиотикам патогенов». При этом для клеток человека он нетоксичен.
После открытия халицина команда загрузила в алгоритм данные о 107 млн химических соединений. Три дня спустя программа выдала список из 23 потенциальных антибиотиков, восемь из которых подтвердили свою эффективность в экспериментах, а еще два могут оказаться особенно сильными. Авторы отмечают, что без использования искусственного интеллекта протестировать такое количество веществ было бы невозможно.
Теперь исследователи намерены использовать алгоритм, чтобы обнаружить молекулы, эффективные против конкретных бактерий. При приеме таких антибиотиков можно будет избежать гибели полезных симбиотических микроорганизмов. Другая задача, которую исследователи также намерены попробовать решить при помощи этого алгоритма, — разработка новых антибиотиков с нуля.
Создание новых антибиотиков — не единственный подход к борьбе с бактериями. Например, австралийские ученые обнаружили, что сочетание уже одобренных препаратов позволяет уничтожать бактерии внутри биопленок. Обычным антибиотикам эта задача не под силу.